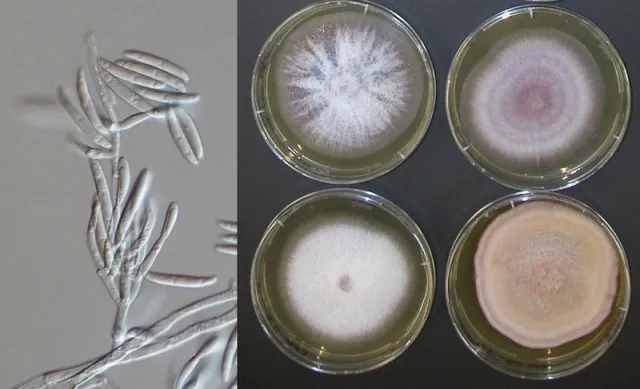

(openPR) Mit den richtigen natürlichen Mitteln einen doppelten Effekt erreichen.
Lindenberg im Allgäu, 26. November 2015. Es gibt natürliche Hilfsmittel, denen man eine durchschlagende Wirkung gegen Pilzinfektionen nachsagt. Die Redaktion von gesund-leben-ratgeber.de stellt dazu sogar einen Doppeleffekt vor.
Eine Gefahr für Pilzinfektionen vermutet man vor allem im Sommer. Beispielsweise wenn man Barfuß durch das Schwimmbad geht und sich dort den Fußpilz holt. Abgesehen davon, dass das auch im Herbst und Winter im Hallenbad möglich ist, gehen die Erfahrungen ganzheitlich orientierter Mediziner viel weiter. Sie wissen, dass Pilzinfektionen sehr oft das Zeichen einer geschwächten Abwehr sind. Gerade im Herbst, wenn das Immunsystem von Erkältungen herausgefordert wird, kann das die Pilzinfektionen so richtig hochtreiben.
Natürliche Lösungen bei Pilzinfektionen
Bei der Recherche nach natürlichen Lösungen ist die Redaktion auf die ätherischen Öle gestoßen. Besonders empfohlen werden die ätherischen Öle von Teebaum, Salbei und Lavendel. Sie sollen dabei helfen, die Keime zu reduzieren und bei der Wundheilung zu helfen. Darüber hinaus sind ätherische Öle für ihren positiven Einfluss auf das Immunsystem bekannt. Deshalb werden sie auch gegen Erkältungen eingesetzt. Man erreicht also damit eine Art von Doppeleffekt, der sie besonders interessant macht.
Darüber hinaus gibt es noch eine ganze Reihe von weiteren natürlichen Mitteln, die bei Pilzinfektionen helfen können. Manche Hilfe gegen Pilzinfektionen findet man sogar in der Küche (www.gesund-leben-ratgeber.de/index.php/bei-pilzinfektionen-hilfe-aus-der-kueche/). Wie beispielsweise der Apfelessig und das Backpulver.
Trotz aller dieser wundersamen Hilfen aus der Natur sollte bei hartnäckigen Pilzinfektionen ein Therapeut hinzugezogen werden. Gerade weil Pilzinfektionen Hinweise auf schwerwiegende Erkrankungen sein können.
Presseinformation
gesund-leben-ratgeber, M+V Medien- und Verlagsservice Germany Unternehmergesellschaft (haftungsbesch
Auch im Herbst drohen Pilzinfektionen


Diese Pressemeldung wurde auf openPR veröffentlicht.
Verantwortlich für diese Pressemeldung:Firmenkontakt
gesund-leben-ratgeber, M+V Medien- und Verlagsservice Germany Unternehmergesellschaft (haftungsbesch
Michael Petersen
Ried 1e
88161 Lindenberg
01714752083

http://www.gesund-leben-ratgeber.de/
Pressekontakt
G.P.T., M+V Medien- und Verlagsservice Germany Unternehmergesellschaft (haftungsbeschränkt)
Michael Petersen
Ried 1e
88161 Lindenberg
01714752083

http://www.gesundheit-presse-texter.de
gesund-leben-ratgeber, M+V Medien- und Verlagsservice Germany Unternehmergesellschaft (haftungsbesch
Michael Petersen
Ried 1e
88161 Lindenberg
01714752083
http://www.gesund-leben-ratgeber.de/
Pressekontakt
G.P.T., M+V Medien- und Verlagsservice Germany Unternehmergesellschaft (haftungsbeschränkt)
Michael Petersen
Ried 1e
88161 Lindenberg
01714752083
http://www.gesundheit-presse-texter.de
Über das Unternehmen
Die Plattform im Internet www.gesund-leben-ratgeber.de informiert darüber, wie man sich ein gesundes und genussvolles Leben einrichtet. Die Redaktion veröffentlicht wöchentlich Tipps und Ratschläge rund um die Gesundheit. Dazu jede Menge Buchtipps, die weiter helfen.
Schließlich werden aktuelle Gesundheitsthemen aufgegriffen und Tipps gegeben, was man tun kann, wenn die Gesundheit beeinträchtigt wird. Das Portal ist ein Wegbegleiter für ein gesundes genussvolles Leben.
Schließlich werden aktuelle Gesundheitsthemen aufgegriffen und Tipps gegeben, was man tun kann, wenn die Gesundheit beeinträchtigt wird. Das Portal ist ein Wegbegleiter für ein gesundes genussvolles Leben.
Pressebericht „Auch im Herbst drohen Pilzinfektionen“ bearbeiten oder mit dem "Super-PR-Sparpaket" stark hervorheben, zielgerichtet an Journalisten & Top50 Online-Portale verbreiten:
Disclaimer: Für den obigen Pressetext inkl. etwaiger Bilder/ Videos ist ausschließlich der im Text angegebene Kontakt verantwortlich. Der Webseitenanbieter distanziert sich ausdrücklich von den Inhalten Dritter und macht sich diese nicht zu eigen. Wenn Sie die obigen Informationen redaktionell nutzen möchten, so wenden Sie sich bitte an den obigen Pressekontakt. Bei einer Veröffentlichung bitten wir um ein Belegexemplar oder Quellenennung der URL.
Weitere Mitteilungen von gesund-leben-ratgeber, M+V Medien- und Verlagsservice Germany Unternehmergesellschaft (haftungsbesch

Bettwanzen Stiche
Ratgeber für das Erkennen und Bekämpfen von Bettwanzen und anderen Parasiten. Ein rechtzeitiges Aufspüren dieses Ungeziefers ist wichtig.
Tipps und Hinweise für das Bekämpfen werden auf dieser Seite praxisnah erklärt.
Auch die Parasiten-Bekämpfung an Haustieren wird gut und nachvollziehbar gezeigt.
https://bettwanzen-stiche.de


Warum Bluthochdruck so gefährlich ist
Tipps, wie man dem Bluthochdruck auf natürliche Weise begegnen kann.
Lindenberg im Allgäu, 04. Mai 2016. Bluthochdruck gilt als stille Zeitbombe für schwere lebensgefährliche Erkrankungen. Was es damit auf sich hat und welche Lösungswege es gibt, das erläutert die Redaktion von gesund-leben-ratgeber.de.
Eigentlich war es ein ganz normaler Morgen. Als Klaus M. aus dem Haus ging, schien für ihn die Welt noch in Ordnung zu sein. Doch das änderte sich bald, als er plötzlich, wie aus heiterem Himmel, von schier unerträglichen Schmerzen in der Br…
Das könnte Sie auch interessieren:

Candida auris: Ein Pilz verlangt Aufmerksamkeit
Ein neuer Verursacher von Pilzinfektionen sorgt für Schlagzeilen in den Medien weltweit. Experten aus Deutschland und Österreich raten jetzt zu erhöhter Aufmerksamkeit. Gleichzeitig warnen sie vor Panikmache.
---
„Gefährlicher Candida auris – Patienten sterben an Hefepilz-Infektion“: Mit dieser Schlagzeile hat vor kurzem eine deutsche Tageszeitung ihre …


Pilzinfektionen nach den Feiertagen
Für Abwehrschwache sind Süßigkeiten besonders kritisch für Pilzinfektionen.
Lindenberg im Allgäu, 30. Dezember 2015. Gerade nach Feiertagen, wie nach Weihnachten, können Pilzinfektionen besonders unangenehm werden. Die Redaktion von gesund-leben-ratgeber.de erläutert, was es damit auf sich hat und was man beachten sollte.
Plötzlich und kurz nach den …

Wenn Schimmelpilze das Auge zerstören
Wer weiche Kontaktlinsen benutzt, sollte sich strikt an die Hygieneregeln halten – sonst kann es zu gefährlichen Pilzinfektionen am Auge kommen. Darauf weisen Mediziner zur „Woche der Pilzerkrankungen“ hin.
---
Weiche Kontaktlinsen im Behälter mit der Aufbewahrungsflüssigkeit an einen sonnigen, warmen Fensterplatz stellen? Schwierig.
Die Aufbewahrungslösung …


Candida - Vorsicht vor Pilzinfektionen
Gesund-leben-ratgeber.de informiert zum Thema Pilzinfektionen, am Beispiel Candida.
Lindenberg im Allgäu, 09. Dezember 2014. Pilzinfektionen sind weit verbreitet und werden oft falsch eingeschätzt. Der Candida ist ein typisches Beispiel dafür. Die Redaktion von erläutert, was das bedeutet und worauf zu achten ist.
Pilzinfektionen sind lästig
Infektionen …


Pilzinfektionen nicht unterschätzen
Kostenloser Ratgeber erläutert, wie man Pilzinfektionen loswerden kann.
Lindenberg im Allgäu, 27. Mai 2015. Pilzinfektionen sind eine häufige Gesundheitsstörung, die man ernst nehmen muss. Die Redaktion von gesund-leben-ratgeber.de erläutert die Hintergründe und stellt einen kostenlosen Ratgeber dazu vor.
Wenn wir von Pilzinfektionen hören, dann denken …


Fußpilz - Badespaß mit Nebenwirkungen
Kostenloser Ratgeber gibt Tipps bei Pilzinfektionen.
Lindenberg im Allgäu, 30. Juli 2015. Fußpilz ist einer der häufigsten Nebenwirkungen des Badevergnügens. Die Redaktion von gesund-leben-ratgeber.de erläutert, worauf man achten sollte und stellt einen kostenlosen Ratgeber dazu vor.
So ein kühles Bad in der Sommerhitze nutzen zahlreiche Menschen um …


Beim Baden angesteckt. Pilzinfektionen mit bösen Folgen.
Was Pilzinfektionen wirklich bedeuten.
Lindenberg im Allgäu, 14. Juli 2016. Der Badespaß sollte eigentlich ein Vergnügen sein. Doch oft endet er mit bösen Folgen. Die Redaktion von gesund-leben-ratgeber.de erläutert, worauf man bei Pilzinfektionen achten sollte.
Eine Abkühlung in der Sommerhitze, da tut ein frisches Bad richtig gut. Doch so unbeschwert, …


Sensibilisierungskampagne zu Pilzinfektionen
… August 2017 die erste sogenannte „Fungal Disease Awareness Week“ – auf Deutsch „Woche der Pilzerkrankungen“ – aus. Die Sensibilisierungskampagne macht auf die Probleme der Pilzinfektionen aufmerksam und rückt die Thematik in die öffentliche Diskussion.
Das Motto der Aktionswoche lautet: „Think Fungus“ – also „Denk' an Pilzinfektionen“. Patienten und Ärzte …


Neues Online-Portal zum Thema Pilzinfektionen gestartet
Pilzinfektionen. Von der Allgemeinheit oft auch als Volkskrankheit bezeichnet. Beinahe jeder Deutsche wird einmal im Leben die Symptome, wie das Brennen, Jucken oder die roten schuppenden Flecken mitgemacht haben. Genau aus diesem Grund haben es uns zur Aufgabe gemacht Ihnen eine Plattform zur Verfügung zu stellen auf der Sie sich über die verschiedenen …


Pilzinfektionen - Schreckgespenst Candida albicans
Kostenloser Ratgeber erläutert Maßnahmen bei Pilzinfektionen mit Candida albicans.
Lindenberg im Allgäu, 25. Juni 2015. Viele Menschen werden von ihm regelrecht gequält. Candida albicans ist einer der häufigsten Pilzinfektionen. Die Redaktion von gesund-leben-ratgeber.de erläutert, worauf man achten sollte und stellt einen kostenlosen Ratgeber dazu vor.
Es …
Sie lesen gerade: Auch im Herbst drohen Pilzinfektionen